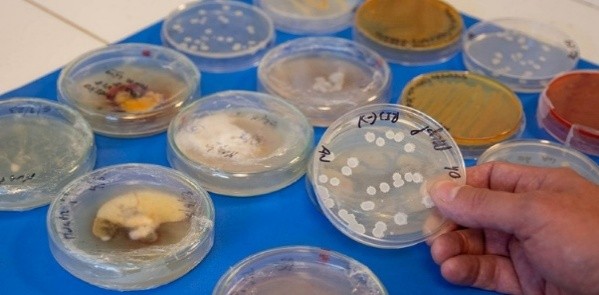

Áreas de Investigación y Desarrollo
El INTA está enfocado en atender y promocionar el desarrollo rural, preservar el ambiente, los recursos naturales y la biodiversidad, bajo un enfoque de territorios, con la participación y acción inclusiva de profesionales y agricultores con el conocimiento y la experiencia para implementar, guiar y orientar correctamente la gestión desarrollada hacia la consolidación de una agricultura sustentable.
Su accionar se enfoca en:
- Generar conocimiento científico y tecnológico para contribuir a la competitividad, funcionalidad y sostenibilidad de los sistemas productivos agropecuarios.
- Facilitar el acceso a productos tecnológicos para mejorar los sistemas productivos agropecuarios.
- Fortalecer la vinculación con productores e instituciones del sector para la atención de demandas tecnológicas y el trabajo colaborativo.
Las investigaciones del INTA destacan por su impacto territorial y su coherencia con los objetivos nacionales de seguridad alimentaria, descarbonización y resiliencia climática.
En el área agrícola, las líneas de trabajo en granos básicos, frutales tropicales, raíces y tubérculos fortalecen la productividad y la autosuficiencia alimentaria. En el ámbito pecuario, los avances en nutrición animal, sistemas silvopastoriles y ganadería baja en carbono reafirman el compromiso del país con la sostenibilidad ambiental. Por su parte, las investigaciones en suelos y laboratorios consolidan la base científica para la toma de decisiones sobre uso del territorio, fertilidad, diagnóstico fitopatológico y biotecnología aplicada.

Frutas Tropicales
Manejo agronómico y mejoramiento genético.

Raíces y Tubérculos
Manejo agronómico, mejoramiento genético y seguridad alimentaria.

Granos Básicos
Mejoramiento genético, manejo agronómico con variedades adaptadas a estrés hídrico y calórico, seguridad alimentaria y alimentación animal.

Hortalizas
Mejoramiento genético, manejo agronómico, materiales para la seguridad alimentaria.

Producción de Semilla de Calidad
Desarrollo y venta de semilla de calidad y vitroplantas adaptadas a diferentes localidades.

Sistemas Pecuarios
Ganado Brahman de alto potencial para mejoramiento del hato nacional y calidad productiva.

Forrajes y Ensilajes
Innovación en forrajes y ensilaje para una ganadería resiliente y productiva.

NAMA´s y Carbono Orgánico del Suelo
Acciones de mitigación, monitoreo, reporte y verificación.

Agricultura de Precisión y Mapeo de Suelos
Cartografía y fertilidad de suelos para la toma de decisiones.

Ambientes Protegidos
Validación de tecnologías adaptadas a diferentes sistemas de producción.
Desarrollo de Bioinsumos
Biocontroladores, biofertilizantes y producción “on farm”.

Laboratorios de Diagnóstico
Biotecnología y análisis para la toma de decisiones tecnológicas.

Gestión del Conocimiento
Fortalecimiento de capacidades técnicas y adopción tecnológica.

Pasantías / Tesis
INTA recibe pasantes de colegios técnicos y universidades nacionales e internacionales.
